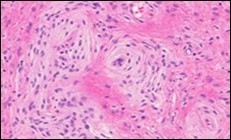

The Neoplastic Whorls-Soft Tissue Perineurioma
Abstract
Perineurioma is an exceptional, benign neoplasm entirely composed of neoplastic perineurial cells and arises from the peripheral nerve. Pertaining to location, the neoplasm predominantly demonstrates configurations such as intra-neural or extra-neural, confined to the soft tissue. Perineurioma was initially scripted by Lazarus and Trombetta in 1978 and is additionally nomenclated as localized hypertrophic neuropathy1. Extra-neural soft tissue perineurioma and mucosal (intestinal) perineurioma are frequent, in contrast to intra-neural perineurioma or localized hypertrophic neuropathy subtype1, 2.
Author Contributions
Academic Editor: Jun Wan, Department of Medical and Molecular Genetics, Indiana University School of Medicine, USA.
Checked for plagiarism: Yes
Review by: Single-blind
Copyright © 2019 Anubha Bajaj,
This is an open-access article distributed under the terms of the Creative Commons Attribution License, which permits unrestricted use, distribution, and reproduction in any medium, provided the original author and source are credited.
Competing interests
The authors have declared that no competing interests exist.
Citation:
Introduction
Disease Characteristics
Intra-neural perineurioma exhibits a proliferation of perineurial cells within the endoneurium. Multiple, concentric layers of perineurial cells circumscribe neural trunks with configuration of typical bulb-like, pseudo-onion articulations. Appearance of pseudo- onion bulbs can be misinterpreted as a reparative or reactive feature on account of organized cellular manifestations. Intra-neural perineurioma can delineate segmental, tubular enlargement of the incriminated nerve. Lesions of intra-neural perineurioma evolve gradually and are accompanied by motor and sensory deficits. Nerve trunks such as the cervical plexus, brachial plexus, intercostal nerves, spinal roots, sciatic nerves and nerves of extremities can be implicated3.
Extra-neural perineurioma is sub classified into categories such as soft tissue perineurioma, sclerosing perineurioma and reticular perineurioma. Perineurioma arises primarily from the skin or soft tissue and is commonly encountered within the extremities, trunk or head and neck. Middle aged adults are affected and a gender predilection is absent. Tumour magnitude varies from 0.3 centimetres to 20 centimetres with a mean of 4.1 centimetres1, 2.
Soft tissue perineurioma, low-grade fibromyxoid sarcoma and intramuscular / cellular myxoma are neoplasms which demonstrate distinct, identical features such as
a) occurrence in middle aged adults with a preponderance of lesions upon the extremities
b) on cytological examination, aforesaid neoplasia enunciate bland, uniform spindle-shaped cells admixed within a myxoid stroma
c) aforementioned neoplasia depict overlapping immune phenotypes1, 2.
Clinical Elucidation
Clinical assessment demonstrates a median age of disease emergence at 45 years with age of disease occurrence varying betwixt 42 years to 60 years, a slight female predominance with a female to male proportion of 3:2. Preferred sites of tumour incrimination are the thigh, toe and perirectal soft tissue. Mean tumour magnitude is 6.6 centimetres2, 4.
Soft tissue perineurioma is a benign neoplasm which reoccurs exceptionally. A broad anatomic distribution of the lesion is encountered, although a majority of individuals display a painless, subcutaneous nodule confined to the limbs.
Soft tissue perineurioma is preponderantly a sporadic neoplasm wherein exceptional tumours can be delineated in subjects with genomic mutations of neurofibromatosis 1 or 2 (NF1 or NF2) gene2, 4.
Histological Elucidation
On gross examination, a well circumscribed nodule of variable magnitude is discerned which appears distinct from an adjoining peripheral nerve. Cytological smears of soft tissue perineurioma are sparse to moderately cellular and exhibit cogent features such as spindle--shaped to ovoid cells with delicate, elongated cytoplasmic processes and an accompanying lack of tumour necrosis2, 4.
Cytological enunciation of tumour cells as predominantly spindle-shaped to ovoid with scant, delicate, cytoplasmic processes demonstrates several cells which are stripped of cytoplasm and an infrequent delineation of morphologically classical, elongated, bipolar cytoplasmic processes. Nuclear atypia or pleomorphism is absent. Scattered stromal fragments intermixed with miniature, thin- walled blood vessels and the cellular component are exemplified4, 5. Cogent features enunciated on cytology are myxoid matrix (20%), lack of nuclear and cellular atypia, spindle-shaped nuclei (60%), bipolar cytoplasmic processes(20%) and vascular configurations (20%). On microscopy, elongated, bland cells appear in parallel bundles or fascicles with the configuration of an occasional storiform pattern. The cellular aggregates can simulate a neurofibroma or Pacinian corpsucle. The circumscribing stroma is collagenous with accompanying peri-cellular clefts. Cellular atypia is absent and mitotic figures are exceptional5, 6.
Soft tissue perineurioma can be indicated if a myxoid lesion exhibits a distinctive storiform or fascicular pattern of tumour evolution. Cellular proliferation can be composed of spindle cells, characteristically demonstrating elongated, thin, delicate, bipolar cytoplasmic processes, a pale-staining, eosinophilic cytoplasm with wavy or tapering nuclei and a finely dispersed nuclear chromatin.
The neoplasm can depict perivascular whorls. Mitotic activity can be observed enumerated as 0-13 /30 high power fields, although around 65% tumours are devoid of mitotic activity. Neoplasms of extensive duration can exhibit foci of degenerative atypia with modifications such as nuclear pleomorphism and nuclear hyperchromasia with intracytoplasmic and intra-nuclear inclusions. Tumour necrosis is generally absent5, 6. Microscopically, a perineurioma composed of bland, ovoid to spindle-shaped cells with elongated, slender nuclei and elongated, bipolar cytoplasmic processes can delineate a storiform, lamellar or a whorled pattern or perivascular aggregates of neoplastic cells are configured, disseminated in a collagenous or focally myxoid stroma. Lesions such as a hybrid schwannoma or perineurioma with features intermediate betwixt a schwannoma and perineurioma can be discerned. Characteristically, bland, ovoid to thinly elliptical, spindle-shaped cells with elongated, delicate, bipolar, cytoplasmic processes are exemplified with a storiform or whorled architectural pattern. Intervening stroma can be myxoid, collagenous or myxo-collagenous5, 6.
Cogent Subtypes Are
Intra-Neural Perineurioma
Intra-neural perineuriomawhich is a neoplasm delineating proliferation of perineurial cells within the endoneurium. Configuration of concentric, repetitive layers circumscribing the nerve with articulation of characteristic pseudo-onion, bulb-like structures are exhibited. Pseudo- onion bulbs can be misinterpreted as a reparative or reactive process on account of organized cellular arrangements. Intra-neural perineurioma can inculcate segmental, tubular enlargement of the incriminated nerve. Remaining nerve fibres, immune reactive to S100 protein, are enveloped by perineurial cells, immune reactive to epithelial membrane antigen(EMA). Intra neural perineurioma is a grade I tumour as per contemporary classification of World Health Organization (WHO) and is devoid of a malignant metamorphoses. Implicated subjects frequently display muscular weakness in concurrence with or absence of obvious muscular atrophy, although sensory disturbances are exceptional. Intra- neural perineurioma is frequent within the peripheral nerves, upper extremities and young adults5.
Extra-Neural Soft Tissue Perineurioma
It is a neoplasm which is devoid of gross association with a peripheral nerve. The neoplasm is miniature, solitary, around 10 centimetres in magnitude, well circumscribed and un-encapsulated. Tumour evolution is variable wherein the storiform pattern is a frequent manifestation. Additionally, the neoplasm can demonstrate a lamellar, whorled, pacinian or a fascicular pattern of growth. The stroma is often collagenous and around 20% instances depict foci of myxoid stromal articulations. Extra-neural perineurioma is commonly delineated within superficial soft tissue of trunk and extremities, especially the hands5, 6.
Sclerosing Perineurioma
It is a variant of extra-neural soft tissue perineurioma and is composed of plump, spindle shaped and epitheloid tumour cells encompassed in a hyalinised stroma. Prominent, thin- walled vasculature is discerned with the emergence of peri-vascular and lace- like arrangement of tumour cells surrounding blood vessels. The neoplasm chiefly occurs within fingers of young male subjects. Reticular perineurioma is a variant of extra-neural soft tissue perineurioma with predominant degenerative, myxoid alterations. Configuration of pseudo-cystic spaces can occur. Tumour cells can demonstrate a lace- like reticular pattern5, 6.
Malignant Perineurioma
It is also cogitated as perineurial malignant peripheral nerve sheath tumour. Malignant perineurioma commonly delineates features such as hyper-cellularity, nuclear atypia, hyperchromasia, enhanced mitotic rate, infiltrative growth and necrosis. Concurrent tumour necrosis is indicative of a category of malignant perineurioma as grade 3, classified by World Health Organization. The neoplasm singularly arises from extra-neural soft tissue perineurioma. As an exceptional tumour, it metastasizes infrequently, in contrast to a conventional malignant peripheral nerve sheath tumour5, 6.
Figure 1, Figure 2, Figure 3, Figure 4, Figure 5, Figure 6, Figure 7, Figure 8, Figure 9, Figure 10, Figure 11
Figure 1.Soft tissue perineurioma with fascicles of bipolar neural cells with elongated cytoplasmic processes, wavy nuclei and an admixture of collagen fibres 11.
Figure 2.Soft tissue perineurioma with lamellar bundles of neural cells demonstrating elongated cytoplasmic processes, wavy, slender nuclei and admixed collagen fibres 12.
Figure 3.Soft tissue perineurioma with whorls and fascicles of neural cells displaying wavy nuclei, elongated cytoplasmic fibrils and intermingling of collagen fibres 13.
Figure 4.Soft tissue perineurioma composed of whorls and perivascular aggregates of neural cells with bipolar cytoplasmic processes, wavy, slender nuclei and commingled collagen fibres 13.
Figure 5.Soft tissue perineurioma /schwannoma with whorls and lamellae of neural cells with bipolar cytoplasmic processes, wavy nuclei and intermingled collagen fibres 14.
Figure 6.Soft tissue perineurioma with foci of spindle cells with wavy nuclei and an admixture of myxoid and collagenous stroma 15.
Figure 7.Soft tissue perineurioma with an abundance of collagen fibrils intermixed with a neural element with bipolar cells with elongated cytoplasm and wavy nuclei 16. 
Figure 8.Soft tissue perineurioma with neural cells exemplifying elongated cytoplasmic processes, slender, wavy nuclei and an abundance of collagenous stroma 17. 
Figure 9.Soft tissue perineurioma with plentiful collagenous fibrils intermixed with lamellar neural tissue with elongated cytoplasmic extensions and wavy, pointed nuclei 18.
Figure 10.Soft tissue perineurioma demonstrating immune reactivity to epithelial membrane antigen EMA18.
Figure 11.Soft tissue perineurioma with whorls of neural cells delineating spindle cells with bipolar cytoplasm and wavy nuclei and an admixture of collagen bundles 19.
Immune Histochemical Elucidation
Soft tissue perineurioma is immune reactive to perineurial markers such as epithelial membrane antigen (EMA) and CD34 besides being immune non reactive to S100 protein or mucin 4 (MUC4). Aforesaid immune phenotype simulates normal perineurial cells. Immune reactivity to EMA is variable and appears as focal, mild, intense, membranous or diffuse and is cogent in highlighting the delicate, bipolar, cytoplasmic processes. Immune reactivity to EMA(100%), Claudin- 1(40%) and CD34 (65%-80%) is demonstrated. Immune reactivity to actins can also be discerned.
Perineurioma is immune reactive to perineurial markers claudin-1 and glucose transporter 1(GLUT1). Perineurial cells and certain soft tissue perineuriomas enunciate the classic tight junction- associated protein claudin-1.76, 7
On electron microscopy, non branching, thin, cytoplasmic processes are observed which are layered by an extraneous lamina and adherent cellular terminals with tight junctions. Organelles are minimal whereas numerous pinocytotic vesicles and filaments of actin and vimentin are discerned. Perineurioma can be detected on cogent ultrastructural examination although can be immune non reactive to EMA.
Molecular studies depict a monosomy of chromosome 22 with genomic deletions at 22q11-13.16, 7.
Differential Diagnosis
Soft tissue perineurioma requires a segregation from conditions such as intra-neural neurofibroma/ schwannoma, intra-neural malignant peripheral nerve sheath tumour, neural lipofibroma, pacinian neuroma, ectopic meningioma, desmoid fibromatosis, smooth muscle tumour, solitary fibrous tumour, superficial acral myxoma or a dermatofibroma6, 7.
Soft tissue perineurioma necessitates a demarcation from benign tumours such as schwannoma, neurofibroma, intramuscular/ cellular myxoma and nodular fasciitis besides malignant conditions as with low-grade fibromyxoid sarcoma, low- grade myxofibrosarcoma, dermatofibrosarcoma protuberans and low- grade malignant peripheral nerve sheath tumour6, 7.
As perineurioma mandates a distinction from neoplasia such as neurofibroma, dermatofibrosarcoma protuberans, cutaneous meningioma and low-grade fibromyxoid sarcoma, specific manifestations can be discerned within diverse lesions.
Immune reactivity to S100 protein and non reactivity to EMA is discerned in schwannoma and neurofibroma. Dermatofibrosarcoma protuberans can resemble a perineurioma, especially upon a superficial biopsy and is immune non reactive to epithelial membrane antigen (EMA). Compact cellular clusters and nuclear atypia is observed in dermatofibrosarcoma protuberans and low-grade malignant peripheral nerve sheath tumour7, 8.
Cutaneous meningioma typically emerges upon the scalp of infants and children and is immune non reactive to CD34.
Certain perineuriomas can simulate a low grade fibromyxoid sarcoma which are immune reactive to MUC4.
Differentiation from nodular fasciitis can be obtained upon a cogent history8, 9.
Meticulous examination of cytological and morphological features can aid the distinction as occurrence of pleomorphism and curvilinear vasculature can be delineated in low- grade myxofibrosarcoma. Cogent tissue sampling can display diagnostic morphological manifestations such as classic architectural features as with a whorled or storiform pattern in soft tissue perineurioma, tumour heterogeneity, diverse cellularity and myxoid or a collagenous stroma in low-grade fibromyxoid sarcoma, along with distinctive tumour infiltration appearing as invasion and splaying out of adjacent skeletal muscle fibres discerned in intramuscular/ cellular myxoma8, 9.
Therapeutic Options
Surgical extermination of the neoplasm along with resection of a perimeter of normal, uninvolved soft tissue is usually curative9, 10.
(Table 1)
Table 1. Differential Diagnosis of Soft Tissue Perineurioma 78910.| Extraneural Perineurioma | Neurofibroma | Low grade fibromyxoid sarcoma | Ectopic meningioma | Desmoid Fibromatosis | Smooth muscle tumour | Solitary fibrous tumour | Superficial acral fibromyxoma | Dermatofibroma | Dermatofibrosarcoma protuberans |
|---|---|---|---|---|---|---|---|---|---|
| Collagenous stroma variable architecture, occasional whorls, absent rosettes and staghorn vessels | Shredded carrot collagen bundles | Occasional giant collagen rosette | Whorled architecture | Ill defined, invasive growth, broad sweeping fascicles | Perpendicular intersecting fascicles | Prominent vascular pattern with staghorn vessels, pattern-less, variable architecture | Classic, storiform architecture | ||
| CD34+, EMA+, Claudin-1+ S100-, MUC4-, | CD34+, EMA+, S100+ | Claudin-1+, focal, weak EMA, MUC4+ | EMA+, Cluadin-1+ | Variable EMA, diffuse CD34 | EMA(50%),CD34+,Claudin-1- | EMA focal or weak | Focal, weak EMA, strong, diffuse CD34, | ||
| Well circumscribed, on subcutaneous tissue | Grossly circumscribed, microscopically infiltrative | Infiltrative growth | Infiltrative growth | ||||||
| Myxoid areas infrequent with insignificant alternating pattern | Myxoid areas definitive with alternating fibrous zones | ||||||||
| Monosomy chromosome 22, STAT6 absent | Typical FUS-CREB3L2 translocation (chromosome 7 and 16) | May express STAT6 | NAB2-STAT6 gene fusion, express STAT6 | Typical COL1A-PDGFB fusion | |||||
| Long, thin, spindle cells, absent psammoma bodies or intranuclear incluions, no epidermal induction | Syncitial epitheloid cells, frequent psammoma bodies and intranuclear pseudoinclusions | Blunt ended nuclei, abundant eosinophilic cytoplasm, | Plump, spindled or epitheloid cells, Hyperplastic epidermis | ||||||
| Nuclear β-catenins absent, infrequent actins | Nuclear β-catenins present, express SMA and MSA | Express actins and desmin | |||||||
| Usually on extremities or trunk, rarely periungual area | Situated on hands, feet, periungual area | Centred on dermis and often invading subcutaneous region |
References
- 1.Lazarus S S, Trombetta L D. (1978) Ultrastructural identification of a benign perineurial cell tumour. , Cancer 41, 1823-1829.
- 2.Antonescu C R, Perry A. (2016) Perineurioma In: Louis DN, Ohgaki H, Wiestler OD, Cavenee WK ed WHO classification of the tumours of the central nervous system-revised fourth edition. , Lyon, France 222-224.
- 3.Wang L M, Zhong Y F. (2014) Intraneural perineurioma affecting multiple nerves: a case report and literature review. , Int J Clin Exp Pathol 7(6), 3347-3354.
- 4.Domanski H A, Mertens F. (2009) Low grade fibromyxoid sarcoma is difficult to diagnose by fine needle aspiration cytology; a cytomorphological study of eight cases. , Cytopathology 20, 304-314.
- 5.Evans H L. (2011) Low grade fibromyxoid sarcoma; a clinicopathologic study of 33 cases with long term follow up. , Am J Surg Pathol 35, 1450-1462.
- 6.Moller E Doyle.(2011).MUC4 is a highly sensitive and a specific marker for low grade fibromyxoidsarcoma. , Am J Surg Pathol 35, 733-741.
- 7.Cates J M, Coffin C M. (2012) Neurogenic tumours of the soft tissue. Paediatr Dev Pathol15(1Suppl): 62-107.
- 8.Schaefer I M, Strobel P. (2013) A soft tissue perineurioma and other unusual tumours in a patient with neurofibromatosis type 1. , Int J Clin Exp Pathol 6(12), 3003-3008.
- 9.Coffin C M, Davis J L. (2014) Syndrome- associated soft tissue tumours. , Histopathology 64(1), 68-87.
